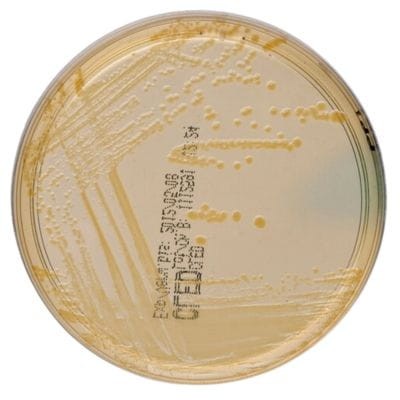
CLED Medium gotowa pożywka na płytkach do wykrywania powszechnych patogenów dróg moczowych

Znaleziono produktów: 287
 Chocolate Agar with Vitox gotowa pożywka na płytkach
Chocolate Agar with Vitox gotowa pożywka na płytkach
Podłoża gotowe na płytkach
Producent:
Oxoid
Cena:
21,70 zł
(netto:
20,09 zł
)
zawiera 8% VAT, bez kosztów dostawy
 Chromogenic Coliform Agar gotowa pożywka do oznaczania Escherichia coli
Chromogenic Coliform Agar gotowa pożywka do oznaczania Escherichia coli
Podłoża gotowe na płytkach
Producent:
Oxoid
Cena:
49,65 zł
(netto:
40,37 zł
)
zawiera 23% VAT, bez kosztów dostawy
CLED Medium gotowa pożywka na płytkach do wykrywania powszechnych patogenów dróg moczowych
CLED Medium gotowa pożywka na płytkach do wykrywania powszechnych patogenów dróg moczowych
Podłoża gotowe na płytkach
Producent:
Oxoid
Cena:
24,51 zł
(netto:
22,69 zł
)
zawiera 8% VAT, bez kosztów dostawy
 Columbia Agar with Sheep Blood PLUS gotowa pożywka z krwią owczą do hemolizy
Columbia Agar with Sheep Blood PLUS gotowa pożywka z krwią owczą do hemolizy
Podłoża gotowe na płytkach
Producent:
Oxoid
Cena:
23,97 zł
(netto:
22,19 zł
)
zawiera 8% VAT, bez kosztów dostawy
 Columbia CNA STAPH/STREP gotowa pożywka na płytkach Petriego
Columbia CNA STAPH/STREP gotowa pożywka na płytkach Petriego
Podłoża gotowe na płytkach
Producent:
Oxoid
Cena:
24,47 zł
(netto:
22,66 zł
)
zawiera 8% VAT, bez kosztów dostawy
 D/E Neutralizing Broth
D/E Neutralizing Broth
Podłoża sypkie
Producent:
Oxoid
Cena:
431,21 zł
(netto:
350,58 zł
)
zawiera 23% VAT, bez kosztów dostawy
 Dermasel Selective Medium gotowa pożywka na płytkach do izolacji grzybów dermatofitowych
Dermasel Selective Medium gotowa pożywka na płytkach do izolacji grzybów dermatofitowych
Podłoża gotowe na płytkach
Producent:
Oxoid
Cena:
33,44 zł
(netto:
30,96 zł
)
zawiera 8% VAT, bez kosztów dostawy
 Dermatophytes Selective Agar (Taplin) gotowa pożywka na płytkach do odróżniania dermatofitów od innych grzybów
Dermatophytes Selective Agar (Taplin) gotowa pożywka na płytkach do odróżniania dermatofitów od innych grzybów
Podłoża gotowe na płytkach
Producent:
Oxoid
Cena:
86,69 zł
(netto:
80,27 zł
)
zawiera 8% VAT, bez kosztów dostawy
 Dichloran Rose-Bengal Chloramphenicol Medium gotowa pożywka na płytkach
Dichloran Rose-Bengal Chloramphenicol Medium gotowa pożywka na płytkach
Podłoża gotowe na płytkach
Producent:
Oxoid
Cena:
73,51 zł
(netto:
59,76 zł
)
zawiera 23% VAT, bez kosztów dostawy
 Dichloran-Glycerol (DG18) Selective Medium gotowa pożywka na płytkach
Dichloran-Glycerol (DG18) Selective Medium gotowa pożywka na płytkach
Podłoża gotowe na płytkach
Producent:
Oxoid
Cena:
35,90 zł
(netto:
29,19 zł
)
zawiera 23% VAT, bez kosztów dostawy
 Dryspot Staphytect Plus Kit test lateksowy
Dryspot Staphytect Plus Kit test lateksowy
Testy diagnostyczne i kontrole
Producent:
Oxoid
Cena:
367,09 zł
(netto:
339,90 zł
)
zawiera 8% VAT, bez kosztów dostawy
 Dyspenser do nanoszenia krążków antybiotykowych 6 pozycyjny
Dyspenser do nanoszenia krążków antybiotykowych 6 pozycyjny
Dyspensery do krążków
Producent:
Oxoid
Cena:
742,66 zł
(netto:
687,65 zł
)
zawiera 8% VAT, bez kosztów dostawy
darmowa i wygodna wysyłka
już od 800 zł netto
Najwyższa jakość
produktów potwierdzona certyfikatami
Zakupy 24h na dobę
wygodne i bezpieczne
bezpłatna konsultacja
z ekspertem online


